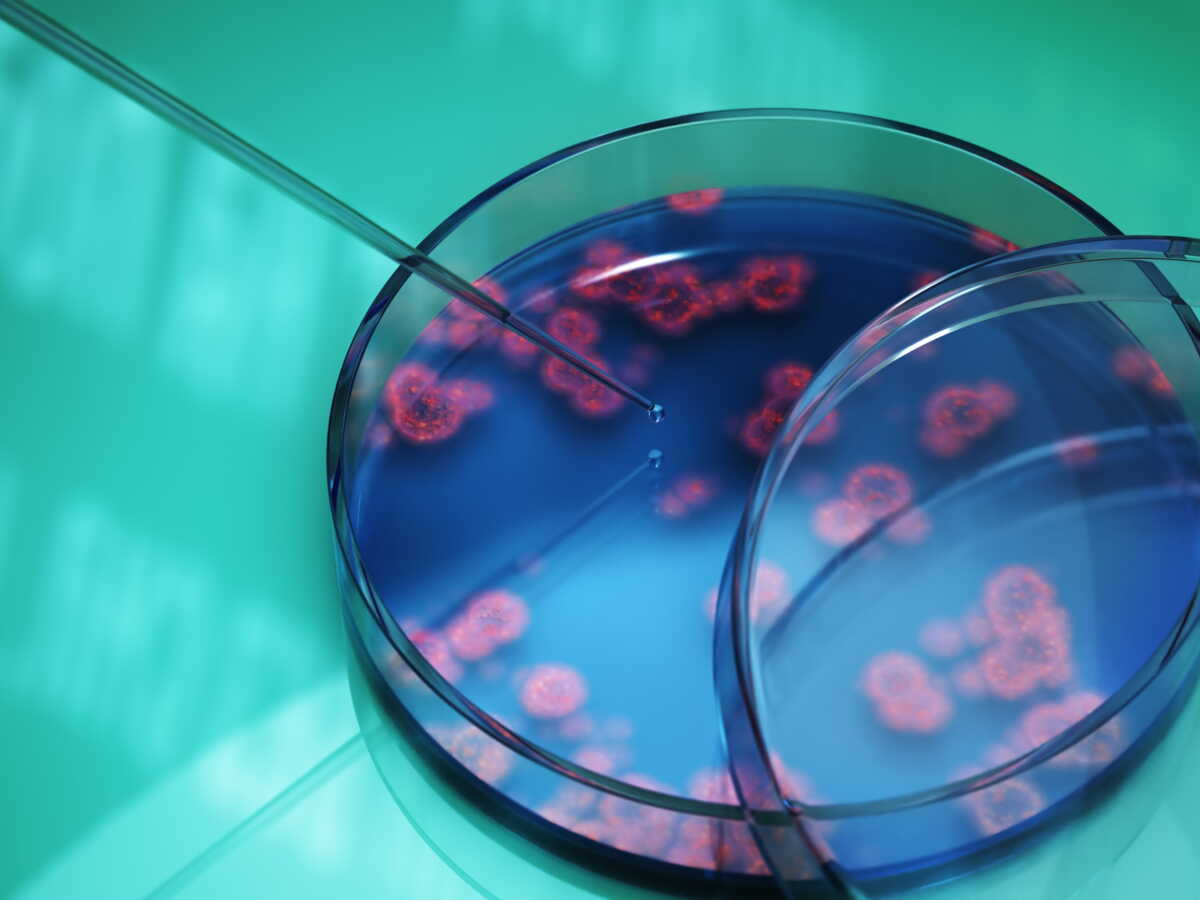

2026-06-15
L’arrivée des médicaments imitant certaines hormones intestinales a profondément changé la manière de traiter l’obésité. Une nouvelle étude clinique ajoute désormais un candidat à cette course scientifique très suivie : le survodutide, un traitement injectable hebdomadaire encore expérimental.

2026-06-11
La médecine moderne ne cesse de nous étonner avec ses avancées spectaculaires. Alors que les techniques de réparation des fractures osseuses étaient longtemps limitées à l’utilisation de plâtres traditionnels et d’interventions chirurgicales, une innovation chinoise pourrait bien bouleverser ce domaine. Un groupe de chercheurs chinois, dirigé par le Dr Lin Xianfeng à l’hôpital Sir Run Run Shaw dans la province du Zhejiang, a développé un adhésif révolutionnaire, capable de réparer une fracture en seulement trois minutes. Appelé le Bone-02, cet adhésif bioabsorbable pourrait devenir une alternative aux méthodes traditionnelles, ouvrant ainsi la voie à une nouvelle ère dans le traitement des fractures.

2026-06-08
Cette version sous-cutanée du traitement anticancéreux Sarclisa était jusqu'à présent administré à l'hôpital. Il pourra désormais l'être par injecteur portable.

2026-06-08
Avaler un petit dispositif médical pour explorer l’estomac n’est plus une idée de science-fiction. Les capsules endoscopiques existent déjà, mais elles restent surtout des caméras passives, portées par les mouvements du tube digestif. Une nouvelle génération de robots miniatures cherche à faire beaucoup plus : se déplacer, mesurer, prélever, puis transmettre des informations utiles au diagnostic. C’est dans cette voie que s’inscrit SeroTab, une mini-tablette robotique souple conçue pour analyser l’environnement gastrique de l’intérieur, sans électronique embarquée classique. Elle ne remplace pas encore l’endoscopie médicale, mais elle montre à quoi pourrait ressembler une exploration digestive moins invasive, plus ciblée et potentiellement plus confortable pour les patients.

2026-06-01
Des chercheurs ont développé un outil innovant pour évaluer et comparer l'efficacité des médicaments antihypertenseurs. Cette avancée promet d'améliorer la gestion de la première maladie chronique

2026-05-29
Des cellules humaines génétiquement modifiées ont accompli un exploit remarquable en régénérant plusieurs organes de primates âgés, comme si le temps avait été partiellement inversé pour leurs tissus. Cette percée expérimentale, bien que préliminaire, dessine un avenir où la lutte contre le vieillissement pathologique pourrait s'appuyer sur nos propres mécanismes biologiques amplifiés.

2026-05-26
Une équipe du CHU de Nantes, avec l’Inserm et l’AP-HP, a identifié une nouvelle piste prometteuse contre l’antibiorésistance, qui cristallise aujourd’hui les préoccupations sanitaires mondiales. Leur étude, menée chez 143 patients traités par antibiotique, montre que certains gènes naturellement présents dans notre microbiote intestinal pourraient aider à empêcher l’installation de bactéries multirésistantes. Explication.

2026-05-25
Des chercheurs ont reproduit les dégâts d'Alzheimer sur les nerfs moteurs sans faire intervenir le cerveau. Les déficits musculaires de la maladie sont donc indépendants des symptômes cognitifs.

2026-05-21
Alors que la maladie d’Alzheimer progresse partout dans le monde, une protéine d’Helicobacter pylori intrigue en bloquant des amas toxiques en laboratoire. Entre risque accru et piste de protection, ce retournement scientifique rebat les cartes du lien intestin‑cerveau.

2026-05-21
Conçu pour comprendre le comportement des cellules individuelles, le modèle Cell2Sentence-Scale 27B a prédit qu'une molécule pouvait améliorer la visibilité des tumeurs pour le système immunitaire. Une hypothèse qui a été confirmée par des tests.

2026-05-15
Un implant cérébral contre la dépression vient d'obtenir l'autorisation de la FDA pour ses premiers essais sur l'humain. Le dispositif, grand comme une myrtille, se pose en 20 minutes sans chirurgie cérébrale classique. Il cible les patients pour qui les antidépresseurs n'ont jamais fonctionné.

2026-05-15
Deux molécules expérimentales sont parvenues, chez l’animal et sur des modèles cellulaires, à relancer la reconstruction de la myéline, cette gaine protectrice détruite par la sclérose en plaques. Une piste encore lointaine, mais qui pourrait changer la manière de traiter la maladie.

2026-05-07
À force de combattre la tumeur, certaines cellules immunitaires finissent par s’encrasser de l’intérieur et par perdre leur puissance. En identifiant l’origine de ce « burn-out » cellulaire, des biologistes américains ouvrent une voie prometteuse pour rendre les traitements contre le cancer plus efficaces.

2026-04-26
Une signature invisible, tapie au cœur du microbiote intestinal, pourrait bien bouleverser notre compréhension de la maladie de Parkinson. Derrière cette avancée scientifique, une promesse fragile mais réelle : repérer plus tôt, agir autrement, et peut-être ralentir l’inéluctable.

2026-04-25
Des chercheurs américains ont mis au point une stratégie expérimentale qui pousse les tumeurs à évoluer dans une direction précise, pour ensuite les frapper au moment où elles deviennent vulnérables.

2026-04-25
Des études cliniques ont été lancées pour tester un cathéter innovant capable de régénérer avec précision et en toute sécurité les tissus cardiaques endommagés à l'aide d'impulsions d'énergie uniques et plus courtes. Une avancée technologique conçue, fabriquée et testée au sein de l'Union européenne

2026-04-19
La douleur persistante emprunterait un chemin nerveux distinct de celle qui alerte face à un danger immédiat. Désactiver ce trajet spécifique soulagerait les patients sans compromettre leurs réflexes de protection.

2026-04-15
Des travaux dévoilent une communication entre cellules sensorielles de l'intestin, capable d'influencer directement les signaux transmis au cerveau. Ce circuit explique comment l'organisme ajuste le comportement alimentaire face à une menace parasitaire, avec des implications bien au-delà des infections aiguës.

2026-04-05
Un nouvel hydrogel injectable à base d’acide hyaluronique permet à la fois de freiner la dégradation articulaire et de visualiser le traitement par imagerie. Une avancée qui pourrait transformer la prise en charge de l’arthrose.

2026-03-27
Et si nous pouvions rajeunir les cellules souches de notre système immunitaire ? Dans une étude collaborative publiée dans Cell Stem Cell, des chercheurs ont exploré une piste prometteuse. En ciblant les "centres de recyclage" de nos cellules, l'équipe a réussi à restaurer certaines propriétés des cellules souches murines âgées. Cette percée offre des perspectives pour vieillir en meilleure santé et développer des traitements contre les cancers du sang.

2026-03-25
Le cartilage articulaire, longtemps considéré comme incapable de se réparer, pourrait finalement être régénéré grâce à de nouvelles approches thérapeutiques. Deux avancées récentes bousculent les certitudes de la médecine.

2026-03-22
Des analyses d’imagerie cérébrale montrent que l’expérience reproductive laisse une signature spécifique à chaque étape de la vie maternelle. Les circuits impliqués dans la cognition sociale, la vigilance et la coordination motrice ne sont pas mobilisés de la même manière selon le nombre d’enfants.

2026-03-15
C’est une première mondiale ! Un traitement à base de cellules souches, révolutionnaire, vient d’être autorisé au Japon pour traiter une maladie grave, la maladie de Parkinson. C’est une thérapie porteuse de nombreux espoirs pour les personnes souffrant de cette pathologie.

2026-03-14
Largement prescrits pour traiter les infections bactériennes, les antibiotiques font partie des piliers de la médecine moderne. Mais une étude scientifique récente menée sur près de 15.000 personnes révèle que certains traitements pourraient perturber durablement l’équilibre des bactéries intestinales, parfois jusqu’à huit ans après leur prise. Publiés dans la revue Nature Medicine, ces résultats mettent en lumière un impact potentiel à long terme sur le microbiote et relancent les discussions autour de l’usage raisonné de ces médicaments, au-delà de la seule question de la résistance aux antibiotiques.

2026-03-13
Une équipe britannique a mis au jour un mécanisme inédit capable de modifier des molécules complexes à un stade avancé de leur synthèse. Cette approche ouvre la voie à des ajustements plus rapides, plus propres et potentiellement moins coûteux pour l’industrie pharmaceutique.

2026-03-11
Le nombre de cancers colorectaux explose chez les jeunes adultes sans facteur de risque connu. Une vaste étude internationale révèle qu'une toxine bactérienne présente dans l'intestin dès l'enfance pourrait provoquer des mutations décennies avant l'apparition de la maladie.

2026-03-09
Des chercheurs ont identifié un mécanisme à l'origine de la maladie d'Alzheimer. Cela pourrait mener à de nouvelles pistes de traitement.

2026-03-08
Des chercheurs de l'Université du Massachusetts ont franchi une étape décisive en créant un neurone artificiel capable de communiquer efficacement avec des neurones biologiques, tout en survivant dans des conditions similaires.

2026-03-08
Au moment où les MICI explosent, une équipe française s’intéresse de près à Faecalibacterium prausnitzii, grande absente du microbiote dans la maladie de Crohn. Que révèle ce dialogue inédit entre bactérie et cellules immunitaires sur les traitements de demain ?

2026-03-07
Certaines tumeurs solides possèdent un cœur pauvre en oxygène, difficile à atteindre par les traitements classiques. Des chercheurs exploitent désormais cette faiblesse biologique en utilisant des microbes capables de s’y installer et d’agir directement au cœur de la masse tumorale.

2026-03-06
Imaginez pouvoir observer les zones profondes du cerveau humain à l’aide d’un simple faisceau de lumière. Ce qui relevait jusqu’ici de la science-fiction pourrait bien devenir réalité. Des chercheurs de l’Université de Glasgow ont réussi un exploit technique que l’on croyait impossible : faire passer de la lumière à travers l’intégralité de la tête d’un adulte vivant. Une avancée qui pourrait transformer notre manière de diagnostiquer et de suivre les troubles neurologiques.

2026-03-05
L’arthrose est aujourd’hui l’une des maladies articulaires les plus répandues au monde. Elle touche des centaines de millions de personnes et constitue une cause majeure de douleur chronique et de handicap. Jusqu’à présent, les traitements visent surtout à soulager les symptômes, sans réellement réparer les articulations abîmées. Mais une nouvelle étude publiée dans la revue scientifique Cell Metabolism pourrait changer la donne. Les chercheurs ont découvert qu’un médicament déjà très connu pour traiter le diabète et favoriser la perte de poids, le sémaglutide, principe actif de l’Ozempic et du Wegovy, pourrait aussi stimuler la réparation du cartilage et ralentir la progression de l’arthrose. Une découverte qui ouvre des perspectives inédites pour la médecine articulaire.

2026-03-03
Mieux comprendre comment le microbiote de l’intestin agit sur le cerveau pourrait ouvrir de nouvelles perspectives pour ralentir la progression de la sclérose en plaques, favoriser la réparation des cellules nerveuses et améliorer la qualité de vie des patients.

2026-03-01
Une avancée scientifique prometteuse pourrait transformer le quotidien de millions de personnes souffrant d'arthrite.

2026-03-01
Stress ou curiosité : quel état d’esprit booste vraiment la mémoire ? Pour y répondre, des chercheurs américains ont mené une expérience originale.

2026-02-25
Des cellules immunitaires modifiées offrent une nouvelle chance aux patients atteints de leucémie T agressive, grâce à une avancée médicale britannique. Cette thérapie innovante pourrait transformer le traitement des cas les plus désespérés.

2026-02-25
Une variation génétique observée en Sardaigne modifie la formation des globules rouges et limite la survie du parasite du paludisme. Cette adaptation issue de la sélection naturelle révèle une vulnérabilité biologique exploitable. Elle ouvre des pistes pour concevoir des traitements capables d’imiter cette résistance naturelle ciblée.

2026-02-24
Des chercheurs américains montrent que des outils capables de générer du code à partir d’instructions en langage naturel peuvent construire des modèles prédictifs fiables en un temps record. Cette accélération pourrait réduire l’un des principaux freins de la science des données et rapprocher plus vite les analyses des applications cliniques.

2026-02-23
Des travaux récents suggèrent qu’un traitement largement prescrit pourrait influencer les mécanismes biologiques associés à l’usure de l’organisme. En agissant sur le métabolisme, l’inflammation et le stress cellulaire, cette molécule intéresse désormais les chercheurs pour son potentiel à prolonger la vie en bonne santé.

2026-02-19
D’après le dernier rapport de l’OMS, il y a 1,4 milliard de personnes myopes dans le monde. Ce trouble de la vision toucherait environ 30 % des adultes et ce chiffre pourrait grimper ces prochaines années puisque cette proportion pourrait dépasser les 50 % d’ici 2050.

2026-02-17
Une équipe de l’Institut de recherches cliniques de Montréal (IRCM) a fait une découverte qui pourrait aider les personnes atteintes d’un cancer qui ne répond pas ou plus aux traitements actuels d’immunothérapie.

2026-02-17
Une série de tests réalisés à la fin des années 1990 sur des personnes âgées en bonne santé a permis de suivre leur évolution cognitive pendant plus de vingt ans, avec des résultats très contrastés selon le type d'exercice pratiqué.

2026-02-15
Depuis cinq à dix ans, la littérature scientifique, souvent générée au Québec par des chercheurs émergents, abonde en études qui suggèrent un autre facteur de risque en lien avec le cancer

2026-02-15
Une découverte révolutionnaire vient bousculer nos connaissances sur le cerveau humain. Des chercheurs de l'Institut Karolinska ont démontré que le cerveau adulte continue à produire de nouveaux neurones. Cette neurogenèse pourrait transformer la compréhension de l'apprentissage et de la récupération après un traumatisme cérébral. Quelles implications cette découverte aura-t-elle sur notre conception du vieillissement neuronal ?

2026-02-12
On les croyait entièrement dédiées à notre défense. Pourtant, dans certaines tumeurs, des cellules immunitaires changeraient discrètement de rôle. Une équipe de l'Université de Genève et de l'Institut Ludwig révèle un mécanisme qui pourrait aider à mieux comprendre, et peut-être mieux prédire, l’évolution de nombreux cancers.

2026-02-11
Les douleurs articulaires ne concernent plus seulement les seniors. Chez les trentenaires et quadragénaires, la dégradation du cartilage progresse souvent en silence pendant des années. Face à cette évolution, les chercheurs s’orientent vers des outils capables d’identifier les premiers déséquilibres biologiques avant l’apparition des limitations fonctionnelles.

2026-02-11
Des scientifiques ont développé un nouveau système d’édition génétique révolutionnaire capable d’intégrer des gènes entiers dans l’ADN humain. Cette avancée pourrait, à terme, offrir un espoir concret aux patients souffrant de maladies génétiques complexes causées par une multitude de mutations différentes.

2026-02-11
Les chercheurs s’intéressent désormais à la rétine comme un terrain accessible pour suivre l’évolution silencieuse de pathologies cérébrales complexes, grâce à l’identification de processus infectieux jusque-là négligés.

2026-02-10
Et si votre ADN comptait bien plus que votre mode de vie pour déterminer la durée de votre existence ? Une étude majeure, publiée dans Science, bouscule une idée largement admise et révèle que la génétique jouerait un rôle largement sous-estimé dans la longévité humaine, ouvrant la voie à une nouvelle compréhension du vieillissement… et à des traitements sur mesure.

2026-02-10
Un mythe s’effondre ! Selon une étude menée sur près de 500 000 Britanniques, les personnes qui présentent un risque génétique élevé de développer une maladie d’Alzheimer ont davantage d’activités sociales variées et sont plus entourées par leur famille.

2026-02-08
Une étude d’envergure menée entre le Canada et le Royaume-Uni révèle que certains schémas mentaux liés à l’inquiétude ou à la rumination pourraient accélérer le déclin cognitif en modifiant directement la structure du cerveau.

2026-02-06
La maladie de Parkinson pourrait être mieux comprise grâce à une étude internationale. Les chercheurs ont identifié le réseau SCAN, une zone cérébrale plus vaste qu'imaginée, responsable des symptômes. Cette découverte promet des traitements plus ciblés et efficaces.

2026-02-06
Un nouveau comprimé, actuellement en phase finale d'essais cliniques, réduit de 60 % le mauvais cholestérol chez les patients à haut risque.

2026-02-05
Une équipe de microbiologistes a testé un outil d’intelligence artificielle sur une question encore confidentielle. Le résultat a surpris jusqu’aux chercheurs eux-mêmes, en révélant une capacité inattendue à formuler des hypothèses scientifiques crédibles sans données expérimentales.

2026-02-05
La polyarthrite rhumatoïde est une maladie inflammatoire auto-immune qui déforme douloureusement les articulations et handicape parfois lourdement les personnes qui en souffrent. Si les traitements se sont améliorés et permettent parfois une rémission, ils ne peuvent garantir une guérison. Pour cette raison, une partie des recherches s’oriente vers la prévention.

2026-02-04
Faut-il mieux réguler le recours aux examens d’imagerie de type scanner ? C’est ce que suggère une étude qui pointe du doigt les conséquences potentiellement néfastes d’un cumul d’expositions aux rayons X.

2026-02-03
Des bulles nanométriques, longtemps ignorées, orchestrent silencieusement la préparation des métastases. En perçant leur fonctionnement et en les reproduisant artificiellement, des scientifiques explorent leur double rôle : facilitatrices de la propagation tumorale et potentielles alliées thérapeutiques ciblées. Une piste concrète émerge pour contrer le cancer à sa source la plus mobile.

2026-02-03
Une étude révèle un lien entre l'ADN néandertalien et la malformation de Chiari, soulignant l'influence de notre héritage génétique ancien sur la santé moderne.

2026-02-02
Une vaste étude américaine menée auprès de plus de 700 000 vétérans suggère que l’adoption de huit habitudes de vie saines dès la quarantaine pourrait être associée à un gain de plus de 20 ans d’espérance de vie.

2026-02-02
Une vaste étude britannique suggère que la ménopause s'accompagne de modifications cérébrales similaires à celles observées dans la maladie d'Alzheimer. Une découverte qui pourrait contribuer à expliquer pourquoi les femmes sont plus touchées que les hommes par les démences.

2026-02-02
Et si tout commençait dans l’intestin ? Une étude révèle comment certaines cellules du système immunitaire intestinal pourraient favoriser la progression de la maladie de Parkinson vers le cerveau, bien avant l’apparition des symptômes. Une découverte avec des enjeux majeurs pour le dépistage et les traitements.

2026-02-02
Alors que les nouveaux traitements contre Alzheimer ciblent les stades les plus précoces de la maladie, les outils capables d’identifier ces phases restent rares. Un test cérébral très court, passif et non invasif pourrait combler ce retard en captant des signaux invisibles aux évaluations classiques.

2026-02-01
Des chercheurs espagnols ont réussi à éliminer complètement des tumeurs pancréatiques chez des souris grâce à une combinaison de trois médicaments. Cette approche innovante évite l'apparition de résistances au traitement, un obstacle majeur dans la lutte contre ce cancer particulièrement agressif.

2026-01-31
Des bactéries vivantes ont été détectées, pour la première fois, à l'intérieur des calculs rénaux les plus fréquents. Une découverte qui suggère qu'elles peuvent jouer un rôle biologique dans leur croissance, leur récidive et qui ouvre de nouvelles pistes thérapeutiques.

2026-01-31
Une étude danoise publiée dans Nature Microbiology éclaire d’un jour nouveau la façon dont le système immunitaire se construit dès la petite enfance, et pourquoi certains enfants développent moins d’allergies que d’autres.

2026-01-31
Des neurones dérivés de cellules souches sont testés pour capter les signaux douloureux à la source, dans les articulations arthrosiques. Cette stratégie vise à réduire la douleur sans bloquer artificiellement le système nerveux, tout en soutenant la régénération des tissus. Une alternative prometteuse face aux traitements conventionnels.

2026-01-28
Une équipe espagnole de chercheurs a développé une trithérapie pour soigner le cancer du pancréas. Le traitement s'est révélé efficace sur des souris.

2026-01-27
La santé bucco-dentaire reflète bien plus que l’état de la bouche. Chez les personnes âgées, elle devient un indicateur important de longévité. Une vaste étude japonaise confirme ce lien.

2026-01-26
Les nouveaux antibiotiques sont devenus une priorité face à la résistance croissante des bactéries. Une équipe a mis au point une méthode automatisée pour en créer rapidement. Elle repose sur des composés métalliques et une chimie hautement contrôlée.

2026-01-25
Une pathologie rare peut suffire à faire s’effondrer l’œil sur lui-même, alors même que la rétine reste capable de voir. En restaurant la structure interne du globe oculaire, une approche médicale inédite ouvre une voie thérapeutique là où les solutions classiques échouaient depuis des années.

2026-01-24
Une technologie à base de peptides cycliques perméables à l'intestin grêle, mise au point par des chercheurs japonais, permet une administration orale efficace de l’insuline.

2026-01-24
L'atézolizumab ou Tecentriq - un anticorps - pourra se faire par injection sous-cutanée pour des patients atteints de certains cancers au Royaume-Uni. Cela réduit considérablement la durée de son administration.

2026-01-24
Les maladies inflammatoires de l’intestin sont en augmentation rapide et toucheront bientôt jusqu’à 1% de la population du pays, mais la cause exacte échappe encore aux médecins.

2026-01-22
Perdre une dent définitive a toujours été considéré comme un verdict biologique irrévocable.

2026-01-21
Dans les tissus de chaque être humain se trouvent des cellules qui n’ont pas le même code génétique que le reste du corps. Transmises pendant la grossesse, ces cellules maternelles interagissent avec le système immunitaire, au point d’être tolérées à vie. Un processus d’éducation cellulaire active en serait la clé.

2026-01-21
Des chercheurs du Centre de génétique humaine (CME) de l'UZ Leuven et de la KU Leuven ont mis au point un test sanguin permettant de détecter les cancers à un stade précoce.

2026-01-19
Grâce à des tissus cérébraux cultivés en laboratoire et analysés par intelligence artificielle, les chercheurs commencent à identifier des signatures neuronales propres à certaines maladies psychiatriques. Une approche qui pourrait transformer la manière dont ces troubles sont compris et évalués.

2026-01-17
Dans une nouvelle étude, des chercheurs danois indiquent qu'une maladie courante pourrait être signe avant-coureur de Parkinson et de la démence à corps de Lewy. Explications.

2026-01-16
Des chercheurs ont identifié deux nouvelles lignées cellulaires chez les souris, potentiellement capables de régénérer dents et os, ouvrant la voie à des avancées médicales significatives.

2026-01-15
Des chercheurs chinois exploitent la mémoire du système immunitaire liée à des virus anciens pour cibler les tumeurs résistantes. Leur technologie reprogramme les cellules cancéreuses pour les rendre identifiables et attaquables, ouvrant une piste innovante pour contourner les échecs fréquents de l’immunothérapie face aux cancers peu mutés.

2026-01-15
Certaines formes de diabète, visibles dès les premières semaines de vie, s’accompagnent de troubles neurologiques graves. Ces liens sont restés longtemps mal compris. Grâce aux avancées en génétique et en biologie cellulaire, les chercheurs comprennent mieux ce phénomène. Une même altération moléculaire peut toucher à la fois le pancréas et le cerveau.

2026-01-15
La maladie de Parkinson est longtemps restée perçue comme une pathologie purement neurologique. Mais une autre piste se précise aujourd’hui. Des bactéries venues de la bouche pourraient jouer un rôle inattendu.

2026-01-14
Selon les premiers résultats, une simple piqûre au doigt pourrait, à l’avenir, permettre d’identifier la maladie d’Alzheimer bien avant l’apparition des symptômes cliniques. C’est ce qui ressort d'une étude menée par le consortium européen PREDICTOM, auquel participent l’UZ Brussel et la Vrije Universiteit Brussel. Cette approche pourrait constituer une alternative plus accessible et moins contraignante aux méthodes diagnostiques complexes actuellement utilisées.

2026-01-13
Grâce à une expérience menée sur la moelle épinière d’embryons de poulet, des biologistes ont constaté lors de la division cellulaire un nombre moins élevé d’organites dans les cellules qui deviendront neurones.

2026-01-13
Contrairement aux idées reçues, la grippe ne se transmet pas automatiquement dès qu’une personne malade se trouve dans la même pièce. Une étude récente montre que certaines conditions précises favorisent ou freinent réellement la propagation du virus.

2026-01-10
Des chercheurs américains ont identifié un lien entre l’accumulation de cellules gliales sénescentes et la survenue de troubles neurologiques liés à l’épilepsie temporale. Leur élimination ciblée a permis de limiter les dommages, ouvrant une voie inédite vers une prise en charge plus efficace.

2026-01-09
Certains effets de la lumière sur notre santé restent largement sous-estimés. Pourtant, une simple variation dans la qualité de l’éclairage au bureau suffit à modifier l’activité métabolique, la dépense énergétique et même l’expression de certains gènes.

2026-01-09
Les personnes qui souffrent de schizophrénie ou de troubles bipolaires ont une espérance de vie réduite. Mais selon des chercheurs britanniques, cette espérance de vie pourrait être rallongée, simplement en buvant du café tous les jours.

2026-01-06
Et si la maladie d’Alzheimer n’était pas aussi irréversible qu’on l’a longtemps cru ? Une nouvelle étude américaine explore une piste inattendue, centrée sur l’énergie du cerveau, et invite à repenser les approches actuelles.

2026-01-06
Il existe au Québec une approche méconnue pour le traitement du cancer de la prostate: la thérapie focale, une méthode peu invasive qui permet de détruire uniquement la partie de la prostate atteinte par la tumeur, tout en préservant les tissus sains.

2026-01-04
Une spécialiste écossaise a réussi à traiter un AVC à distance grâce à la robotique. Une première mondiale à réaliser pour l’instant sur un porc, mais qui ouvre la voie à des interventions quand le chirurgien est loin du patient.

2026-01-01
Les grandes maladies cognitives ne surgissent pas de manière brutale au fil du vieillissement. De nouvelles données suggèrent que des événements très précoces, parfois antérieurs à l’enfance, influencent la trajectoire cérébrale sur plusieurs décennies, avec des effets mesurables bien plus tard.

2026-01-01
Une étude majeure révèle des facteurs de risque insoupçonnés liés à la démence précoce. Quels sont les éléments qui influencent l'apparition de cette maladie chez les moins de 65 ans ? Des chercheurs britanniques et néerlandais ont identifié 15 facteurs clés, offrant de nouvelles perspectives pour la prévention et le traitement.

2026-01-01
Normalement, les neurones adoptent un positionnement bien précis au cours du développement. Mais il arrive que des cellules, ou leurs progéniteurs, aillent se positionner en dehors du cortex

2025-12-30
D’après une étude publiée dans Aging Cell, un médicament prescrit pour traiter l'hypertension (la rilménidine) pourrait contribuer à ralentir les effets du vieillissement et à prolonger la durée de vie.

2025-12-29
Vos capacités physiques atteignent leur apogée à l’âge de 35 ans. Mais ce n’est pas un effondrement brutal, c’est une érosion silencieuse qui commence bien avant que vous ne le sentiez vraiment. Une étude suédoise monumentale, menée sur près d’un demi-siècle, a mis en lumière le mécanisme exact de ce tournant biologique inévitable. Plongeons dans cette science du vieillissement pour comprendre non seulement pourquoi ce déclin de nos capacités physiques est programmé, mais surtout comment en maîtriser le rythme infernal.

2025-12-28
Une étude portant sur 35 000 personnes s’est penchée sur les liens entre santé cardiovasculaire et vieillissement cognitif. Elle explore l’impact d’une prise en charge de l’hypertension, notamment par traitements médicamenteux, sur le maintien des fonctions cérébrales et de la santé mentale avec l’âge.

2025-12-27
Une avancée prometteuse vient de surgir dans la lutte contre la maladie d'Alzheimer. Des chercheurs américains ont découvert une molécule capable de restaurer la mémoire chez des souris présentant des symptômes similaires à ceux de cette pathologie neurodégénérative. Cette percée scientifique pourrait-elle marquer un tournant dans le traitement d'une maladie qui affecte des millions de personnes à travers le monde ?

2025-12-27
Des chercheurs de l’université de Stanford ont établi deux paliers auxquels le corps vieilli drastiquement, et cela commence plus tôt que vous ne le pensez.

2025-12-26
Ce qui compte, ce n’est pas la distance mais la manière : une étude britannique montre que la durée des marches à pied joue un rôle clé pour réduire les risques de maladies cardiovasculaires et de mortalité.

2025-12-21
Une avancée médicale spectaculaire redonne espoir aux patients atteints de Parkinson. Des greffes de cellules souches dans le cerveau montrent des résultats prometteurs, avec une amélioration durable des symptômes moteurs chez les premiers patients traités. Cette thérapie cellulaire, après vingt-cinq ans de recherche, pourrait-elle enfin offrir une solution à cette maladie neurodégénérative qui touche des millions de personnes ?

2025-12-20
Les dernières données cliniques montrent que certaines complications graves après l’accouchement pourraient être évitées grâce à une meilleure prise en charge en salle de naissance. Une vaste étude britannique révèle un levier méconnu dans la prévention de ces événements.

2025-12-20
Les émotions durables ne se limitent pas à l’esprit. Des travaux récents montrent que l’équilibre psychologique modifie directement la quantité et l’activité de certaines cellules chargées de la surveillance biologique, modifiant la capacité de l’organisme à réagir face aux agressions.

2025-12-19
Un implant médical révolutionnaire parvient à redonner la vision à des patients atteints de dégénérescence liée à l’âge

2025-12-16
Une vaste étude de l’Inserm révèle que l’exposition de femmes enceintes au méthylparabène et au bisphénol S peut entraîner anxiété et troubles de l’attention chez leurs enfants. Ces résultats renforcent les appels à interdire toute la famille des bisphénols dans les produits du quotidien.

2025-12-15
Une étude a exploré le lien entre l'inflammation chronique, le système immunitaire et le développement du cancer, notamment dans les intestins. Les chercheurs ont identifié un mécanisme par lequel certaines cellules immunitaires, en particulier un sous-type de lymphocytes TH17, peuvent contribuer à la formation du cancer, bien que ce processus puisse être inhibé par des molécules produites par les cellules épithéliales. Cette découverte soulève des questions sur l'usage prolongé des immunothérapies qui stimulent ces lymphocytes et ouvre la voie à de nouvelles thérapies préventives ciblant ce sous-type pour réduire le risque de cancer.

2025-12-13
Le déploiement du dispositif "Neuroclues" au ChWapi de Tournai est une première en Belgique. Ce processus permet de dépister des maladies neurodégénératives, dont celle de Parkinson.
2025-12-13
Des chercheurs explorent de nouvelles voies de diagnostics et de traitements. Ces projets en développement apportent l'espoir de mieux soigner des maladies délicates.

2025-12-13
Des scientifiques viennent de reconstituer un mécanisme génétique vieux de plusieurs dizaines de milliers d’années. En modifiant des souris avec une version archaïque d’un gène humain, ils ont observé les mêmes déformations osseuses que celles retrouvées sur les squelettes fossiles. Cette découverte offre une fenêtre fascinante sur la biologie de nos cousins disparus.

2025-12-12
La corrélation entre la naissance par césarienne et l’augmentation du risque de contracter une leucémie infantile avait déjà été étudié précédemment. Une nouvelle étude suédoise semble confirmer ces soupçons.

2025-12-12
Après avoir tenté de transplanter de vieilles cellules souches (à l’origine des cellules sanguines) dans une jeune moelle osseuse, des scientifiques testent une nouvelle méthode pour retarder le vieillissement.

2025-12-10
Mesurer la glycémie sans douleur ni capteur sous la peau, c’est le pari relevé par une équipe du MIT grâce à une technologie lumineuse issue de la recherche biomédicale. Un pas décisif vers des capteurs miniatures, discrets, et accessibles au plus grand nombre.

2025-12-10
En collaboration avec des chercheurs internationaux, des équipes de l’UCLouvain ont mis en évidence un mécanisme capable de ralentir l’apparition de la maladie. Une avancée qui souligne, une fois encore, l’importance d’une alimentation équilibrée.

2025-12-10
Une étude bouleverse notre compréhension du vieillissement capillaire. Les cheveux gris, loin d’être une simple manifestation de l’âge, pourraient refléter un mécanisme de défense cellulaire crucial face au cancer de la peau. Une découverte qui éclaire d’un jour nouveau les liens entre vieillissement et oncologie.

2025-12-10
En utilisant des cellules immunitaires modifiées et prêtes à l'emploi, une équipe britannique a réussi à obtenir des rémissions profondes chez des patients atteints d'une leucémie T très agressive. Ce traitement révolutionnaire ouvre une nouvelle voie pour ceux que la médecine ne pouvait plus aider.

2025-12-09
Comment aider notre corps à se réparer après une blessure ? Trouver et produire les bonnes molécules qui stimulent la régénération cellulaire reste un défi pour la médecine régénérative. Mais l’intelligence artificielle assiste maintenant les chercheurs pour réussir à concevoir le composé chimique idéal.

2025-12-09
Des scientifiques ont étudié l'ADN d'une femme décédée à 117 ans. Le but : comprendre comment il est possible de vivre aussi vieux, et s'il y a des individus naturellement « doués » pour cette prouesse. Y aurait-il un élixir de vie à notre portée ?

2025-12-07
Pour la première fois, 15 patients ont testé cette solution pour réduire le cholestérol et ça a fonctionné : "C'est vraiment sans précédent"

2025-12-05
Certaines pathologies induisent une perte de tissus comme du cartilage. Il y a donc un réel besoin de greffons. Et si la solution était de cultiver ce cartilage en laboratoire, à partir des propres cellules du patient (et en se servant de pommes) ?

2025-12-04
Le tardigrade, créature microscopique capable de survivre au vide spatial et aux radiations mortelles, a cessé d’être une simple curiosité biologique pour devenir la clé d’une avancée majeure. Récemment, des équipes de chercheurs ont réussi l’impensable : intégrer une séquence spécifique de l’ADN de cet animal indestructible au cœur de cellules humaines. Loin d’être une chimère de science-fiction, cette manipulation a conféré aux tissus humains une protection spectaculaire contre les agressions extérieures. Cette percée scientifique, qui défie les frontières entre les espèces, ouvre des perspectives vertigineuses pour la médecine de demain et la conquête spatiale.

2025-12-04
Des chercheurs de l’Université de Tours publient une étude qui décrypte le comportement des tumeurs. Ils ont mis au point une méthode, basée sur l’intelligence artificielle, qui ouvre la voie à des diagnostics plus fins et à des thérapies adaptées à chaque patient.

2025-12-03
Les taux d’incidence mondiaux du psoriasis devraient continuer d’augmenter jusqu’en 2050. Explications.

2025-12-03
Les personnes qui souffrent d’une apnée du sommeil non traitée ont prés de deux fois plus de risque de souffrir de la maladie de Parkinson.

2025-12-02
Au sommaire de "la planète des sciences" cette semaine : l'aventure intérieure d'un micro robot, une découverte sur le sens de l'orientation des pigeons et les prouesses d'une louve qui interrogent les scientifiques...

2025-12-02
L'Afrique du Sud, l'Eswatini et la Zambie ont commencé lundi à administrer les premières doses d'un traitement préventif du VIH, ce qui constitue la première utilisation de ce médicament très prometteur en Afrique, continent le plus touché par la pandémie.

2025-12-02
Les calculs rénaux représentent une douleur intense pour de nombreux patients. Une équipe internationale cherche à révolutionner leur traitement. Grâce à des technologies de pointe, de nouvelles solutions émergent.

2025-12-01
L’Organisation mondiale de la santé publie lundi, pour la première fois, des directives sur la manière dont ces médicaments, commercialisés sous les noms d’Ozempic, de Wegovy ou de Mounjaro, peuvent aider les personnes obèses à surmonter ce grave problème de santé.

2025-12-01
Une vaste étude britannique révèle cinq grandes phases cérébrales chez l'humain, avec des points de bascule à 9 ans, 32 ans, 66 ans et 83 ans. Contrairement à l'idée reçue du «cerveau adulte» à 25 ans, notre adolescence s'étendrait jusqu'au début de la trentaine.

2025-11-30
De nouvelles études internationales ont caractérisé les bactéries intestinales déséquilibrées des patients souffrant d’infarctus du myocarde, d’angine de poitrine et d’insuffisance cardiaque.

2025-11-29
D’après des chercheurs de l’université de Cambridge, notre cerveau traverserait cinq phases au cours de la vie, chacune ayant ses propres spécificités.

2025-11-28
Des chercheurs ont découvert qu'un simple changement alimentaire, comme l'ajout de pistaches à l'alimentation du soir, peut transformer la diversité bactérienne du côlon chez les adultes prédiabétiques. Cette découverte pourrait offrir une alternative non invasive pour prévenir les troubles métaboliques.

2025-11-24
De nouvelles recherches montrent que les échanges humains reposent sur bien plus que des mots ou des gestes. Les chercheurs ont désormais la capacité de mesurer l’ajustement subtil des rythmes neuronaux entre deux individus, révélant une dimension cachée de la communication qui influence fortement l’attention, la compréhension et l’empathie.

2025-11-24
Des analyses menées sur plusieurs milliers de dossiers médicaux montrent que certains traitements du diabète pourraient influencer la trajectoire du vieillissement féminin. Cette piste ouvre une réflexion plus large sur les liens entre médicaments chroniques, santé métabolique et survie à un âge avancé.

2025-11-24
Les chercheurs ont identifié plusieurs facteurs qui ont aidé la femme la plus âgée du monde, Maria Branyas Morera, à vivre jusqu'à 117 ans, notamment une génétique favorable, un système immunitaire robuste, un faible niveau d'inflammation et un corps qui vieillissait plus lentement que son âge réel. De plus, son hygiène de vie saine, son optimisme, et des relations sociales fortes ont contribué à sa longévité exceptionnelle

2025-11-23
Oméprazole, pantoprazole, lansoprazole… Ces médicaments anti-acide, regroupés sous le nom d’inhibiteurs de la pompe à protons (IPP), figurent parmi les produits les plus prescrits dans l’Hexagone. Leur efficacité n’est pas discutée. Mais depuis quelques années, une série d’études internationales évoque un possible sur-risque de cancer gastrique en cas d’usage prolongé. Alors, simple frémissement scientifique ou vrai sujet de santé publique ?

2025-11-22
Les chercheurs alertent : cette hormone des reins peut rallonger l'espérance de vie de 17 ans si elle est activée à temps

2025-11-22
La stratégie la plus utilisée est celle des "anti-checkpoints" – des médicaments qui "retirent les freins" du système immunitaire –, mais d'autres émergent : vaccins, cellules modifiées ou virus oncolytiques, capables de détruire les cellules cancéreuses tout en réveillant l'immunité

2025-11-21
Les médecins auraient-ils la main trop lourde sur les médicaments antireflux ? Ils ont, en tout cas, tendance à beaucoup les prescrire pour limiter les effets gastriques des anti-inflammatoires. Y compris lorsque cela n’est pas nécessaire.

2025-11-20
Efficaces sur des souris, des cellules qui détruisent les tumeurs vont être testées sur l'homme dans un an à Genève et Lausanne.

2025-11-20
Des chercheurs ont découvert des effets positifs de l'hydralazine contre le glioblastome, un cancer du cerveau

2025-11-17
Avez-vous déjà essayé de mesurer votre niveau de créativité ? Le test DAT (Divergent Association Task) offre une solution rapide et innovante pour évaluer cette faculté si difficile à quantifier. En seulement quelques minutes, ce test permet d'obtenir un aperçu intriguant de votre capacité à penser de manière divergente – une compétence essentielle dans notre monde qui valorise toujours plus l'innovation.

2025-11-17
Des chercheurs sont parvenus à transformer des cellules de l’estomac humain pour qu’elles produisent de l’insuline. Une avancée spectaculaire qui pourrait, un jour, libérer les diabétiques des injections à vie.

2025-11-17
Les analyses d’imagerie menées au cours des premiers mois de suivi mettent en évidence une stabilité inattendue du système glymphatique. Cette stagnation, observée malgré la diminution des plaques, invite à repenser les approches thérapeutiques et à considérer la maladie sous un angle plus global.

2025-11-16
Une étude menée par des chercheurs de l’Université Queen Mary de Londres et de l’University College London a révélé que les humains possèdent une forme de toucher à distance, ou la capacité de percevoir les objets sans contact direct, un sens que certains animaux possèdent également.

2025-11-16
Une chercheuse ontarienne vient d’identifier des gènes associés à la dépendance au cannabis. Ses travaux s’ajoutent à de nombreuses pistes génétiques envisagées pour le dépistage et le traitement des abus de marijuana.

2025-11-14
Une étude sur des rongeurs suggère que, passé un certain âge, le risque de cancer aurait tendance à diminuer, suggérant que le vieillissement serait un atout sinon une arme contre le cancer.

2025-11-13
En 2024, deux études ont apporté de nouveaux éléments. Dans la première , principalement menée à l'université de Chengdu, les chercheurs ont constaté qu'un apport supplémentaire de 100 g de sucre par jour augmentait de 28% la probabilité de développer une dépression.

2025-11-13
Quelle est la part de l’environnement, en particulier social, de l’épigénétique et de la génétique dans les manifestations de l’intelligence (ou des intelligences) chez l’enfant et chez l’adulte ? Explications avec deux scientifiques.

2025-11-12
Vous êtes plutôt du matin ou plutôt du soir ? Quand il est question de performances cognitives, il existe un créneau dans la journée où notre cerveau est le plus performant, selon les scientifiques.

2025-11-10
Des milliers de minuscules particules en suspension s’invitent chaque jour dans notre organisme. Certaines pénètrent jusqu’au cerveau, où elles pourraient accélérer la dégradation des cellules nerveuses impliquées dans la mémoire et le raisonnement.

2025-11-08
La radiothérapie à faible dose apparaît comme une option efficace et sûre pour soulager la douleur liée à l’arthrose légère à modérée, selon plusieurs études présentées lors du congrès annuel de l’American Society for Radiation Oncology (ASTRO) à San Francisco.

2025-11-07
En dix ans, les autodiagnostics de difficultés cognitives se sont envolés parmi les jeunes adultes aux États-Unis. Loin d’être anecdotiques, ces chiffres traduisent une pression mentale croissante et une vulnérabilité jusqu’ici sous-estimée.

2025-11-07
Des chercheurs américains ont montré que la présence de caries et de maladie liée aux gencives présenterait un risque accru d’accident vasculaire cérébrale.

2025-11-06
Et si la maladie d’Alzheimer ne faisait pas que voler les souvenirs ? Une équipe américaine révèle qu’elle dérègle aussi l’horloge interne du cerveau, bouleversant le rythme des cellules chargées de nettoyer les fameuses plaques amyloïdes.

2025-11-05
Une étude présentée à l’American Heart Association a suggéré un lien entre la prise régulière de mélatonine et un risque accru d’insuffisance cardiaque et de mortalité.

2025-10-29
Certaines personnes sont-elles plus fragiles à cause de leur groupe sanguin ? Nous avons posé la question au Pr Jean-Daniel Tissot, hématologue et ancien doyen de la Faculté de biologie et de médecine de Lausanne.

2025-10-08
Un groupe de chercheurs chinois a injecté des cellules souches modifiées à des macaques pendant plusieurs semaines. La plupart des organes des singes ont montré des signes de rajeunissement. Dans "Bonjour ! La Matinale TF1", Anicet Mbida revient sur cette étude prometteuse, si certains points d'ombre sont élucidés.

2025-10-08
Les chercheurs de l'Université du Massachusetts ont réussi à créer le premier neurone artificiel capable de communiquer silencieusement avec des neurones biologiques, tout en survivant dans les mêmes conditions qu’eux.

2025-10-07
L’immunothérapie a révolutionné le traitement du cancer, sauf pour les très nombreux patients qui n’y sont pas réceptifs. Des chercheurs viennent de découvrir une nouvelle molécule capable de rendre les cellules tumorales visibles au système immunitaire.

2025-10-06
Réduire les métastases sans aggraver l’instabilité génétique : une nouvelle cible moléculaire change la donne. En agissant sur un régulateur épigénétique clé, des chercheurs ont identifié un levier biologique insoupçonné pour bloquer la propagation de cellules cancéreuses agressives. Une approche précise qui pourrait redéfinir certaines stratégies anticancer.

2025-10-01
De nombreux problèmes restent à régler pour garantir l'efficacité et la stabilité de cette technique révolutionnaire, mais celle-ci pourrait à terme ouvrir la voie à de nouveaux traitements contre l'infertilité.

2025-09-29
Dans les tumeurs, le système immunitaire reste souvent aveugle. Pour briser ce silence, des scientifiques ont conçu un micro-organisme capable de déclencher localement une riposte immunitaire structurée, sans recourir à des substances chimiques ou à des cellules modifiées en laboratoire.

2025-09-26
La conscience humaine est peut-être l’un des concepts philosophiques et biologiques, qui a le plus traversé les âges. Platon ou Aristote s’interrogeait déjà sur les origines de celle-ci, il y a plus de 2 000 ans ; René Descartes a popularisé au XVIIᵉ siècle son cogito ergo sum (« je pense, donc je suis ») et d’autres génies de l’ère moderne comme Edmund Husserl ou Jean-Paul Sartre au XXᵉ siècle ont maintenu ce concept au centre des débats philosophiques.

2025-09-26
Elle a traversé deux guerres mondiales, une pandémie mondiale et plus d’un siècle d’innovations scientifiques. Pourtant, c’est son propre organisme qui fascine aujourd’hui les chercheurs. Grâce à une analyse inédite de ses tissus, gènes et bactéries intestinales, le cas de Maria Branyas Morera pourrait bien éclairer les mécanismes les plus profonds du vieillissement.

2025-09-24
Pathologie neurodégénérative rare, la maladie de Huntington touche environ 6.000 personnes en France. Pour la première fois, des chercheurs britanniques sont parvenus à traiter la maladie avec succès grâce à une thérapie génique expérimentale.

2025-09-23
Pouvant être présente chez les individus de tout âge, la dépression est un trouble psychique qui toucherait 280 millions de personnes à travers le monde d’après les chiffres de l’Organisation mondiale de la santé (OMS). Maladie invisible, elle se caractérise par de nombreux symptômes qui impactent directement l’individu et son entourage et peut avoir une issue parfois fatale dans 5 à 20% des cas d’après l’Inserm.

2025-09-23
Selon une étude française publiée le 19 septembre dans la revue iScience, dix jours dans un environnement stimulant suffiraient à préserver la mémoire de manière durable chez des souris atteintes de démence.

2025-09-21
Les cellules de votre corps « vomissent » pour vous guérir : la surprenante découverte qui révolutionne notre compréhension de la régénération

2025-09-16
Si le sommeil agit sur de nombreux mécanismes de notre organisme, des chercheurs ont mis en évidence son rôle dans l’élimination des déchets et toxines du cerveau, impliqués dans le développement de la démence.

2025-09-15
Non, le cerveau ne décline pas dès que l’on a passé la vingtaine. Une équipe de chercheurs allemands a récemment mis en évidence que notre capacité à réfléchir plus ou moins vite ne diminuait pas avant l’âge de 60 ans. Précisions avec Thomas Boraud, directeur de l’Institut des maladies neurodégénératives de l’université de Bordeaux.

2025-09-13
Une étude internationale révèle que le cerveau humain adulte génère encore de nouveaux neurones dans l’hippocampe. Cette découverte remet en question un dogme en neurosciences et ouvre la voie à des perspectives inédites pour la santé cérébrale. Elle pourrait transformer notre vision de l’apprentissage, de la mémoire et du traitement de maladies comme Alzheimer.

2025-09-13
Une équipe de chercheurs a découvert que l’intensité d’un appel infantile pouvait provoquer, chez l’adulte, des modifications physiques immédiates. Ces transformations invisibles à l’œil nu pourraient un jour aider à mieux comprendre les signaux de détresse des nourrissons.

2025-09-12
Une découverte qui pourrait changer la vie de plus d’un demi-milliard de personnes dans le monde.

2025-09-11
Des chercheurs japonais ont récemment réussi à éliminer le chromosome supplémentaire que l’on trouve dans les cas de trisomie 21. Cette opération est un espoir pour la recherche, notamment pour traiter les maladies neuromusculaires.

2025-09-10
Notre corps cache un paradoxe fascinant : des cellules mutées, capables de devenir cancéreuses, cohabitent en silence dans nos tissus sains.

2025-09-03
Une équipe de chercheurs espagnols vient de mettre en évidence la fabrication de nouvelles cellules cérébrales par le cerveau humain jusqu’à l’âge de 90 ans. Cette découverte pourrait notamment permettre de diagnostiquer à un stade précoce les personnes touchées par la maladie d’Alzheimer.

2025-09-02
Une étude randomisée montre que dans l'arthrose du genou, l'utilisation excessive de la radiographie peut renforcer chez les patients l'idée qu'un remplacement articulaire est nécessaire et nuire à l'efficacité du traitement médical, dont l'exercice physique.

2025-08-24
Ces traitements injectables, conçus à l’origine pour réguler la glycémie, séduisent désormais un large public en quête de minceur. Mais leur effet sur la microcirculation oculaire soulève un débat scientifique inattendu.

2025-08-22
Des chercheurs de l'UCLouvain ont découvert que les trois couches distinctes qui composent l'enveloppe des bactéries agissent de concert pour assurer leur protection, remettant en question le modèle longtemps admis selon lequel une seule couche jouait un rôle prépondérant.

2025-08-22
Un implant cérébral a permis à un homme souffrant d’une dépression sévère depuis l’adolescence de ressentir de la joie pour la première fois en plus de trente ans.

2025-08-20
Des chercheurs repoussent les limites de la longévité humaine. Grâce à la génétique et à la technologie, une vie de plusieurs siècles n’est plus de la pure science-fiction. Mais entre avancées prometteuses et implications terrifiantes, cette perspective soulève de sérieuses questions.

2025-08-19
Au cœur d’une matrice synthétique conçue pour imiter l’utérus humain, des scientifiques ont capté les toutes premières interactions physiques entre un embryon et son environnement. Cette prouesse technologique dévoile un comportement inattendu, mêlant force, adaptation et stratégie cellulaire.

2025-08-18
Surprise pour beaucoup, l’activité la plus protectrice n’a rien d’apaisant. Elle refuse la contemplation simple. Elle mise sur l’effort, la nouveauté et un engagement. En pratique régulière, on entraîne le cerveau comme un muscle. Les défis progressifs réveillent la mémoire, affûtent le jugement et soutiennent l’adaptation. On gagne en clarté. Ce cadre motive sans stress et installe des repères solides.

2025-08-17
Selon les experts, cela pourrait déboucher sur de nouvelles options de traitement du cancer. Des scientifiques américains ont trouvé un moyen de détruire les cellules cancéreuses en stimulant les molécules avec une lumière proche de l'infrarouge et en les faisant vibrer.

2025-08-17
Et si le vieillissement n’était pas qu’une fatalité, mais un processus que l’on pouvait ralentir ? Des chercheurs sud-coréens ont identifié une molécule qui pourrait bien jouer un rôle clé dans la propagation de l’inflammation et de la vitesse à laquelle nous vieillissons. Encore mieux : certaines pistes existent déjà pour la bloquer.

2025-08-10
Au cœur de nos cellules se trouve l'ADN, support du code de la vie. Christophe Galfard explore sa structure, son rôle dans la fabrication des protéines et son implication dans l'hérédité et l'évolution.

2025-08-07
Le lithium pourrait être un élément clé permettant de résoudre de nombreux mystères liés à la maladie d’Alzheimer et au vieillissement cérébral, selon des chercheurs de la Harvard Medical School.

2025-08-06
La Food and Drug Administration (FDA) américaine a approuvé mercredi un médicament de Jazz Pharmaceuticals, nommé Modeyso, pour traiter le gliome diffus de la ligne médiane (GDM), une tumeur cérébrale rare et agressive qui touche principalement les enfants et les jeunes adultes.

2025-08-05
Bien que leur rôle soit moins connu que celui des neurones, les astrocytes sont des cellules essentielles au fonctionnement du cerveau.

2025-08-05
Il est désormais établi que les troubles du spectre autistique (TSA) ou autisme sont d’origine multifactorielle, c’est-à-dire qu’ils se déclarent chez des personnes génétiquement prédisposées après exposition à un ou plusieurs facteurs environnementaux encore inconnus.

2025-08-04
Une vaste étude a trouvé que les gros consommateurs de café souffrent moins de diabète, maladies cardiovasculaires, et de certains cancers, ce qui réduit leur risque de mortalité. Une autre confirme.

2025-08-03
En confrontant des volontaires à des visages infectés simulés, une équipe suisse a mis en évidence un lien direct entre perception du danger et mobilisation immunitaire. Le cerveau semble capable de transformer un simple signal social en alerte biologique.

2025-08-03
L’étude génétique d’un garçon qui est incapable de ressentir la douleur a permis d’identifier une protéine qui pourrait servir au développement d’une nouvelle génération d’analgésiques contre la douleur chronique.

2025-08-02
Le 26 juillet 2025, Thaddeus Daniel Pierce est né dans l’Ohio. Jusque-là, rien d’exceptionnel — sauf que cet enfant est issu d’un embryon congelé depuis plus de 30 ans, un record mondial. Fruit d’une fécondation in vitro (FIV) réalisée en 1994, cet événement remet en lumière des enjeux éthiques, médicaux et sociétaux majeurs.

2025-08-01
Face au cancer, l'innovation est souvent perçue comme une course contre la montre. Qui, dans son entourage, n'a pas déjà espéré voir poindre une réelle avancée pour rendre la maladie moins redoutable ? Ces derniers mois, une découverte française suscite l'espoir : un tout nouvel outil génétique, fruit du travail de l'INRS, capable de cibler l'ADN simple brin avec une précision que l'on pensait inatteignable. Cette trouvaille pourrait chambouler les stratégies actuelles, et ouvrir des pistes inédites pour soigner ou même prévenir certains cancers jusque-là réputés résistants aux traitements. Mais faut-il pour autant croire à une révolution imminente autour de cette innovation ?

2025-07-31
L'acide urique, une substance provenant, entre autres, de la dégradation des noyaux des cellules contenues dans les aliments (en particulier des produits d'origine animale) peut déclencher les crises de goutte lorsqu'il y en a en trop grande quantité dans le sang. L'acide urique se dépose alors sous forme de cristaux dans les articulations, ce qui provoque une inflammation. La goutte est souvent associée à une consommation excessive d'alcool ou d'aliments trop riches en purines. La personne atteinte est dérangée par une douleur soudaine au gros orteil. Il arrive également que d’autres articulations soient touchées comme celles des doigts, des coudes, des genoux ou des chevilles.

2025-07-31
Un tournant biologique se produit dans notre organisme sans que nous en ayons conscience. Ce point de bascule modifie le fonctionnement profond de nos organes, ouvrant la voie à des interventions médicales mieux ciblées selon l'âge réel de chaque système.

2025-07-27
Cette percée scientifique pourrait bouleverser la disponibilité des traitements anticancéreux les plus prescrits, en s’appuyant sur des micro-organismes pour contourner les méthodes industrielles traditionnelles.

2025-07-25
En combinant deux traitements anti-cancer, des chercheurs ont observé une amélioration de la mémoire et une réduction des lésions cérébrales chez des souris atteintes de la maladie d’Alzheimer.

2025-07-24
En influençant les signaux hormonaux liés à l’envie de sucre, certains microbes intestinaux pourraient bouleverser notre compréhension des mécanismes métaboliques à l’œuvre dans le diabète de type 2.

2025-07-24
Avec l’âge, la mort cellulaire incontrôlée favorise des maladies graves comme Alzheimer ou l’insuffisance rénale. Des chercheurs ont mis au point un traitement prometteur pour bloquer ce processus et lutter contre le vieillissement.

2025-07-23
L'équipe de recherche de l'Institut Rega de la KULeuven a découvert un médicament qui pourrait contribuer à lutter contre les formes graves du paludisme, a annoncé mercredi l'université louvaniste. Ce traitement, le ruxolitinib, pourrait en particulier être utilisé pour combattre l'inflammation et la carence en sucre développées en cas de forme sévère de la malaria.

2025-07-23
Une récente étude parue le 18 juillet 2025 dans la revue Nature Biomedical Engineering fait état de résultats surprenants et convaincants pour la future mise au point d’un vaccin universel destiné à lutter contre le cance

2025-07-22
En France, d’après les dernières estimations, 1,2 million de personnes pourraient être touchées par Alzheimer ou une maladie apparentée.

2025-07-03
Les hormones comme la génétique influent sur le déclin de la cognition avec l'âge, concluent de nouvelles études dans une série spécialement consacrée à la santé des femmes. Historiquement oubliées des recherches cliniques, la biologie féminine et ses conséquences apportent cependant un éclairage bénéfique à tous les sexes.

2025-06-16
Des chercheurs ont prouvé qu'il était possible de réveiller le virus du VIH lorsque celui-ci est latent et caché à l'intérieur de nos cellules. Cette étape, jusqu'alors impossible, pourrait permettre de cibler puis d'éliminer le virus. Un concept qui n'a pas encore été testé chez l'être humain.

2025-06-07
Une nouvelle étude scientifique permettrait libérer les cellules contaminées par le VIH du virus. Une étape importante vers la création d'un traitement curatif de la maladie.

2025-06-07
Une découverte inédite ouvre la voie à une médecine du cancer plus douce, sans chimiothérapie ni rayons. Une équipe coréenne a réussi à reprogrammer des cellules cancéreuses pour qu’elles redeviennent normales.

2025-06-01
La recherche est résolument en phase optimiste à l’Institut de recherche sur le cancer de l’Université de Sherbrooke (IRCUS). Découvrez ou redécouvrez cinq avancées prometteuses issues de nos laboratoires, qui pourraient révolutionner le dépistage et le traitement du cancer.

2025-06-01
Quelques minutes à peine après l’apparition de graves lésions hépatiques, un mécanisme de régénération se met en place. Grâce à un traitement à base de glutamate, l’organe se remet à neuf en quelques jours seulement chez la souris. Un espoir pour le traitement de la cirrhose ou du cancer du foie.

2025-05-30
Labellisée par la Ligue depuis l’année 2018, l’équipe de Raphaël Rodriguez (Institut Curie, Paris) exploite l’addiction des cellules cancéreuses pour le fer afin de développer une nouvelle stratégie thérapeutique contre les tumeurs les plus agressives. Publiés dans Nature, ses derniers résultats constituent une avancée majeure dans cette voie en décrivant comment de petites molécules peuvent cibler et tuer les cellules cancéreuses qui résistent aux traitements actuels et sont à l’origine des métastases[1]. Sont également associées à ces travaux deux autres équipes labellisées, celles dirigées par Juan Iovanna et Christophe Ginestier (Centre de recherche en cancérologie de Marseille).

2025-05-30
Une immunothérapie expérimentale développée pour les chiens atteints d'un cancer des os pourrait bientôt changer la prise en charge de l'ostéosarcome chez les enfants. Une société biopharmaceutique américaine mise sur notre similarité génétique pour accélérer les traitements.

2025-05-30
Le 2 juillet 2024, l’autorité de santé des États-Unis (FDA) a approuvé un nouveau traitement de la maladie d’Alzheimer, le Kisunla (donanemab). Cette approbation marque un tournant important dans la lutte contre la maladie d’Alzheimer. Cette décision a suivi un avis unanime et favorable du comité scientifique consultatif de la FDA.

2025-05-30
Si l’on imagine tous avancer dans la vie en gardant l’œil pétillant, la première ride du temps ne passe pas toujours par la peau ou la mémoire. Elle apparaît là où on ne l’attend pas : au centre même de la vision. Ce petit cristallin, discret mais essentiel, commence à montrer quelques signes de fatigue dès l’enfance, avançant en silence derrière nos paupières, bien avant que la mémoire ou la peau ne fassent défaut. Prendre conscience de cette réalité peu visible, c’est déjà se donner une longueur d’avance face à cette course du vieillissement, en surveillant les tout premiers flous du regard.

2025-05-29
Avec des antidépresseurs, les globules blancs chargés de s'attaquer aux tumeurs sont bien plus efficaces, selon une récente étude. Des résultats prometteurs dans la lutte contre le cancer.

2025-05-29
Un traitement tout simplement « révolutionnaire » contre la narcolepsie pourrait bientôt être disponible, tant les résultats des essais cliniques de phase II récemment publiés par le New England Journal of Medicine sont impressionnants, estime un chercheur québécois.

2025-05-29
Une thérapie cellulaire régénérative, bientôt à l’essai, pourrait bien traiter les lésions de la moelle épinière, longtemps considérées comme incurables. Un espoir pour des millions de personnes paralysées.

2025-05-27
À Dallas, des scientifiques ont mis au point un traitement expérimental qui utilise des protéines modifiées et de la lumière infrarouge pour attaquer les cellules cancéreuses.

2025-05-27
Pendant des décennies, la mitose (processus de division cellulaire) a été enseignée comme un processus rigoureux, presque mécanique.

2025-05-26
Une équipe de recherche américaine est parvenue à synthétiser une petite protéine capable de se comporter comme un prion. En étudiant son repliement, les scientifiques espèrent mieux comprendre certains troubles neurologiques, comme la maladie d’Alzheimer.

2025-05-20
De plus en plus de jeunes sont touchés par le cancer colorectal. Les chercheurs essaient de comprendre pourquoi. Aujourd’hui, une équipe évoque le rôle joué par une toxine produite par une bactérie du microbiote intestinal.

2025-05-10
Des chercheurs du centre de recherche en dermatologie de l'Université de Manchester au Royaume-Uni ont découvert fortuitement qu’un traitement contre l’ostéoporose favorisait la croissance des cheveux. Il permettrait d'aller à la source du problème et d'empêcher la perte de cheveux pour de bon et il pourrait convenir aussi bien aux hommes qu’aux femmes.

2025-05-09
Le trouble de stress post-traumatique Après un événement particulièrement intense émotionnellement, certaines personnes peuvent souffrir d'un traumatisme accompagné de nombreux symptômes. Flashbacks, cauchemars, hypervigilance permanente, stress, troubles du sommeil… Un événement violent peut profondément affecter la vie quotidienne et la santé mentale des personnes qui en ont été victimes ou témoins. On parle de trouble du stress post-traumatique. Un nouveau traitement révolutionnaire pourrait venir en aide à celles qui sont résistantes aux traitements classiques.

2025-05-09
Et si le corps pouvait apprendre à se défendre seul (ou presque) contre certains cancers ? C’est le principe de l’immunothérapie : stimuler les défenses immunitaires pour qu’elles ciblent et éliminent les cellules tumorales.

2025-05-02
Une simple analyse d'urine pourrait bientôt révolutionner le dépistage du cancer de la prostate. Des chercheurs ont mis au point un test non invasif, combinant intelligence artificielle et biomarqueurs, qui surpasse largement le test PSA actuel en termes de précision. Cette avancée promet de détecter la maladie plus tôt, d'éviter des biopsies inutiles et d'offrir un dépistage plus accessible aux hommes.

2025-04-30
La longueur des télomères, qui protègent les bouts des chromosomes, détermine en partie la longévité. Cette longueur dépend en grande partie de processus qui se jouent avant la naissance de l’individu.

2025-04-27
L’IA ne remplace pas encore les biologistes, mais les aide à trouver ce qui échappe aux outils classiques.

2025-04-27
Une étude portant sur 35 000 personnes s’est penchée sur les liens entre santé cardiovasculaire et vieillissement cognitif. Elle explore l’impact d’une prise en charge de l’hypertension, notamment par traitements médicamenteux, sur le maintien des fonctions cérébrales et de la santé mentale avec l’âge.

2025-04-25
Ce nouveau dispositif est implantable par injection. Il est biodégradable et se décompose tout seul après son utilisation, évitant ainsi toute chirurgie pour l’extraire.

2025-04-25
La chirurgie cérébrale est l'une des disciplines les plus complexes et délicates de la médecine. Les patients ayant besoin d'interventions dans leur cerveau font face à des risques considérables, car de nombreuses zones sont responsables de fonctions motrices et cognitives cruciales. De plus, l'accès à certaines régions du cerveau reste techniquement impossible ou très risqué. C'est dans ce contexte que la start-up française Robeauté révolutionne la neurochirurgie avec le développement d'un microrobot neurochirurgical d'une précision inédite. Après avoir levé 27 millions d'euros, l'entreprise a pour objectif de transformer cette technologie en un outil incontournable pour les chirurgiens du futur.

2025-04-19
Certaines localités combinent végétation intense, faible ventilation naturelle et pollution, créant un environnement particulièrement hostile pour les voies respiratoires.

2025-04-17
Deux études ont réalisé une prouesse similaire et quasi simultanée au Japon et en Amérique du Nord : greffer avec succès des neurones producteurs de dopamine à des malades de Parkinson. Les patients n'ont souffert d'aucun effet indésirable grave et ont montré une amélioration de leurs symptômes.

2025-03-11
La réduction de la douleur par un placebo provient de neurones agissant au niveau du cortex préfrontal, à l’avant du cerveau, rapporte une équipe japonaise dans la revue Science Advances.

2025-03-11
Ces réveils nocturnes répétitifs perturbent le repos et peuvent signaler un déséquilibre physiologique. Certaines causes sont bénignes, d’autres nécessitent une attention particulière. Décrypter les mécanismes en jeu permet d’agir efficacement pour retrouver un sommeil plus serein.

2025-03-07
La protéine Dsup permet aux tardigrades, les animaux les plus résistants sur Terre, de résister remarquablement bien aux radiations. Chez la souris et le cochon, elle réduit significativement les dommages de la radiothérapie sans diminuer son efficacité contre le cancer.

2025-01-05
Alors que le nombre de cas de cancer du pancréas augmente en France, des chercheurs ont identifié une piste susceptible de permettre l'exploration de nouvelles voies de recherche.

2025-01-05
Les recommandations de prise en charge de la fibrillation atriale étaient attendues. Plusieurs éléments sont d’emblée notables : l’algorithme de prise en charge, appelé CARE, permet de ne plus rater un des éléments de la prise en charge qui ne peut se limiter au traitement antiarythmique ou anticoagulant.

2025-01-01
Une étude menée au pôle psychiatrie du CHU de Saint-Etienne par des infirmières montre l’efficacité de séances d’hortithérapie sur l’anxiété. Une approche complémentaire facile à mettre en place pour améliorer le bien-être des patients hospitalisés, quelque soit leur trouble.

2025-01-01
Aucune des échelles de la douleur existantes dans le monde n’évalue correctement la douleur chez les nouveaux-nés, y compris les prématurés, alerte l'ONG de médecins Cochrane.

2024-12-29
Pour combattre l’insuffisance cardiaque, maladie du cœur encore trop souvent mortelle, des scientifiques américains se sont lancés dans la mise au point d'une thérapie génique à base de protéine et de virus et dont les premiers résultats s'avèrent prometteurs.

0000-00-00
La viscosité cellulaire pour évaluer le risque de métastase